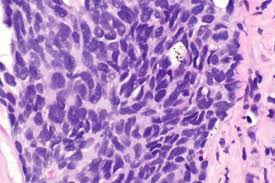

Will Mobocertinib be reimbursed by medical insurance?
Mobocertinib (Mobocertinib) is a drug used to treat non-small cell lung cancer (NSCLC). It is specifically an oral drug used to treat EGFR gene mutation-positive advanced or metastatic NSCLC.
Mobotinib is currently on the market in China, but it is not included in medical insurance. Patients need to pay for it in full, so the price is very high. Please consult the local hospital pharmacy for specific prices. Other versions include the Hong Kong version of the original drug Mobotinib, which costs around 7,000 to 8,000 yuan. The generic drug of Mobotinib is mainly a Laotian generic drug. The price is about three to four thousand yuan, which is nearly half cheaper than the original drug. The ingredients of the original drug and the generic drug are the same.
Adult patients usually take the dose 160mg orally once daily. It can be taken with or without food, but should be avoided with fatty foods to reduce the risk of side effects. Dosage adjustments may be necessary based on the patient's hepatic function or drug interactions.
Common side effects include diarrhea, rash, fatigue, nausea, vomiting, loss of appetite, headache, etc. Serious side effects may include abnormal liver function, interstitial pneumonia, and prolongation of the electrocardiogram QT interval. Patients should have regular monitoring of liver function and electrocardiogram. Patients should tell their doctors about their history of drug allergies and any underlying heart problems. Mobosetinib may cause serious skin reactions such as Stevens-Johnson syndrome, and patients should tell their doctor immediately about any skin abnormalities.
Mobosetinib is an important treatment option that provides an effective treatment pathway for EGFRgene mutation-positive NSCLC patients, especially those who have developed resistance to other drugs. Patients should closely follow their doctor's recommendations when using the medication and be monitored regularly to ensure safe and effective treatment.
[ 免责声明 ] 本页面内容来自公开渠道(如FDA官网、Drugs官网、原研药厂官网等),仅供持有医疗专业资质的人员用于医学药学研究参考,不构成任何治疗建议或药品推荐。所涉药品可能未在中国大陆获批上市,不适用于中国境内销售和使用。如需治疗,请咨询正规医疗机构。本站不提供药品销售或代购服务。
.jpeg)


















